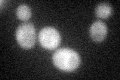

View description
E2-like enzyme involved in autophagy and the cytoplasm-to-vacuole targeting (Cvt) pathway; plays a role in formation of Atg8p-phosphatidylethanolamine conjugates, which are involved in membrane dynamics during autophagy and Cvt
Localization:
Intensity:
Fold change:
Significance:
-
C’ GFP library in SD

cytosol25.89 -
N' NOP1pr-GFP in SD

cytosol71.9235 -
N' TEF2pr-mCherry in SD

cytosol115.04 -
N' NATIVEpr-GFP in SD

cytosol30.7642 -
N' TEF2pr-VC and Cyto-VN in SD

cytosol47.4096 -
C’ GFP library in SD+DTT

cytosol33.511.29No -
C’ GFP library in SD+H2O2
cytosol41.661.6Yes -
C’ GFP library in Starvation Media

cytosol59.352.29Yes -
C’ GFP library on the background of Pup2-DaMP

cytosol -
C’ GFP library on the background of CCT mutant

cytosol31.65331.22248No
